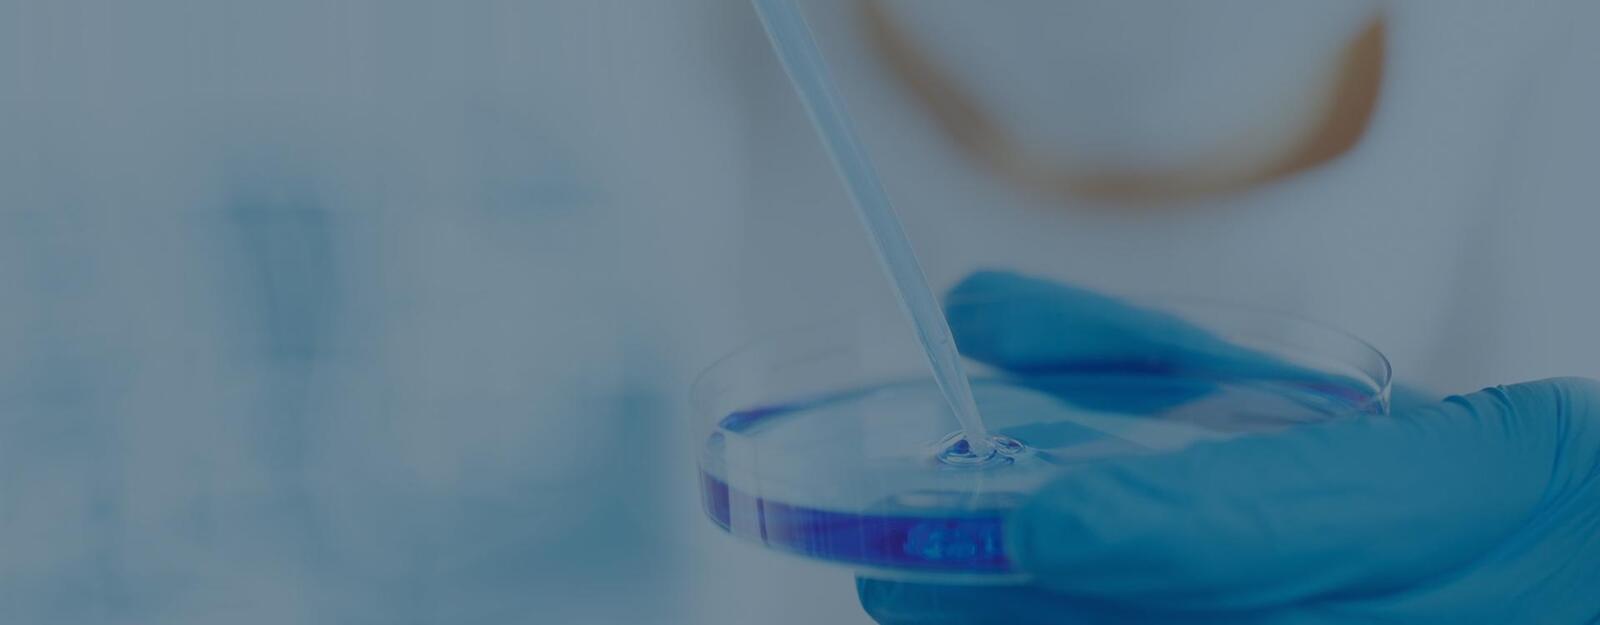

- Home
- Upgrade & Subscriptions
- Blogs
- Articles
- News
- Ad Board
- Marketplace Products
- Marketplace Stores
- UniqueThis Institute
- Service Booking
- Crowdfunding
- Events
- Videos
- Pictures
- Audio
- Forums
- Listing Pages
- Page Directory
- Businesses Pages
- Questions
- Thoughts
- Prayers
- Wishes
- Quotes
- Recipes
- Polls
- Testimonials
- Likes
- Discussions
- Documents
- Gifts
- Petition
- Clips
- Games
- Members
- Hashtags
- Browse Compliments
- Tutorials
- Contests
- Credits
- FAQs
- Groups
- Travel
- Classifieds
- Jobs Worldwide
- Jobs at UniqueThis
- Contact Us
- About Us
- Terms Of Service
- Privacy Policy
- User Data Policy
- Cookies & Other Storage Technologies
- Privacy Center
- General Data Protection Regulation (GDPR)
- California Consumer Privacy Act (CCPA)
- Digital Millennium Copyright Act (DMCA)
- Do Not Sell My Personal Information
- Android App
- iPhone App
- Facebook Page
- X Page
- YouTube Page
- Instagram Page
- Trademark
- Pay UniqueThis
- UniqueThis, Inc. © 2025